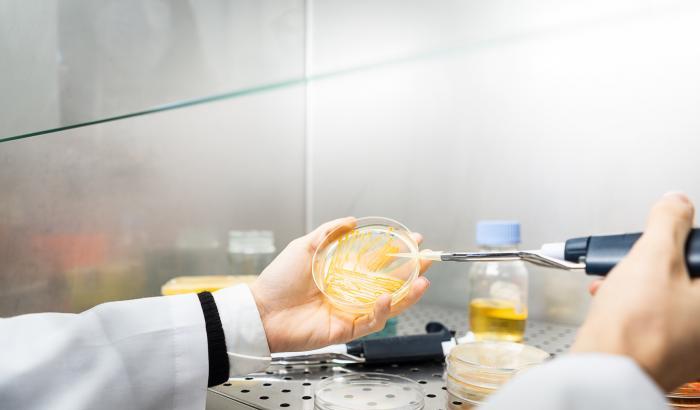
Micro-Val: i batteri "mangia plastica" per riciclare i rifiuti organici

Niente più torte al cioccolato da Ikea, che ne ha bloccato la vendita nelle caffetterie di 23 Paesi dopo che le autorità sanitarie cinesi vi hanno trovato tracce di batteri che solitamente indicano una contaminazione fecale. Le torte sono state bloccate anche in tutti i ristoranti del gruppo in Italia.
I risultati delle prime analisi sui campioni, secondo quanto si apprende, sono attesi nelle prossime 48 ore.
Le autorità sanitarie cinesi, oltre alle torte al cioccolato del gruppo Ikea, hanno bloccato anche lotti di formaggi della Kraft, barrette al cioccolato della Nestlè e creme solari della Shiseido poiché «sotto gli standard» qualitativi.
247 articoli alimentari e cosmetici importati sui quali, lo scorso gennaio, le autorità cinesi hanno rilevato problemi di tipo qualitativo. Gli articoli bloccati includono bevande, cioccolata, biscotti, formule per bambini, dolci, snacks, passata di pomodoro e brandy.
[GotoHome_Torna alla Home]